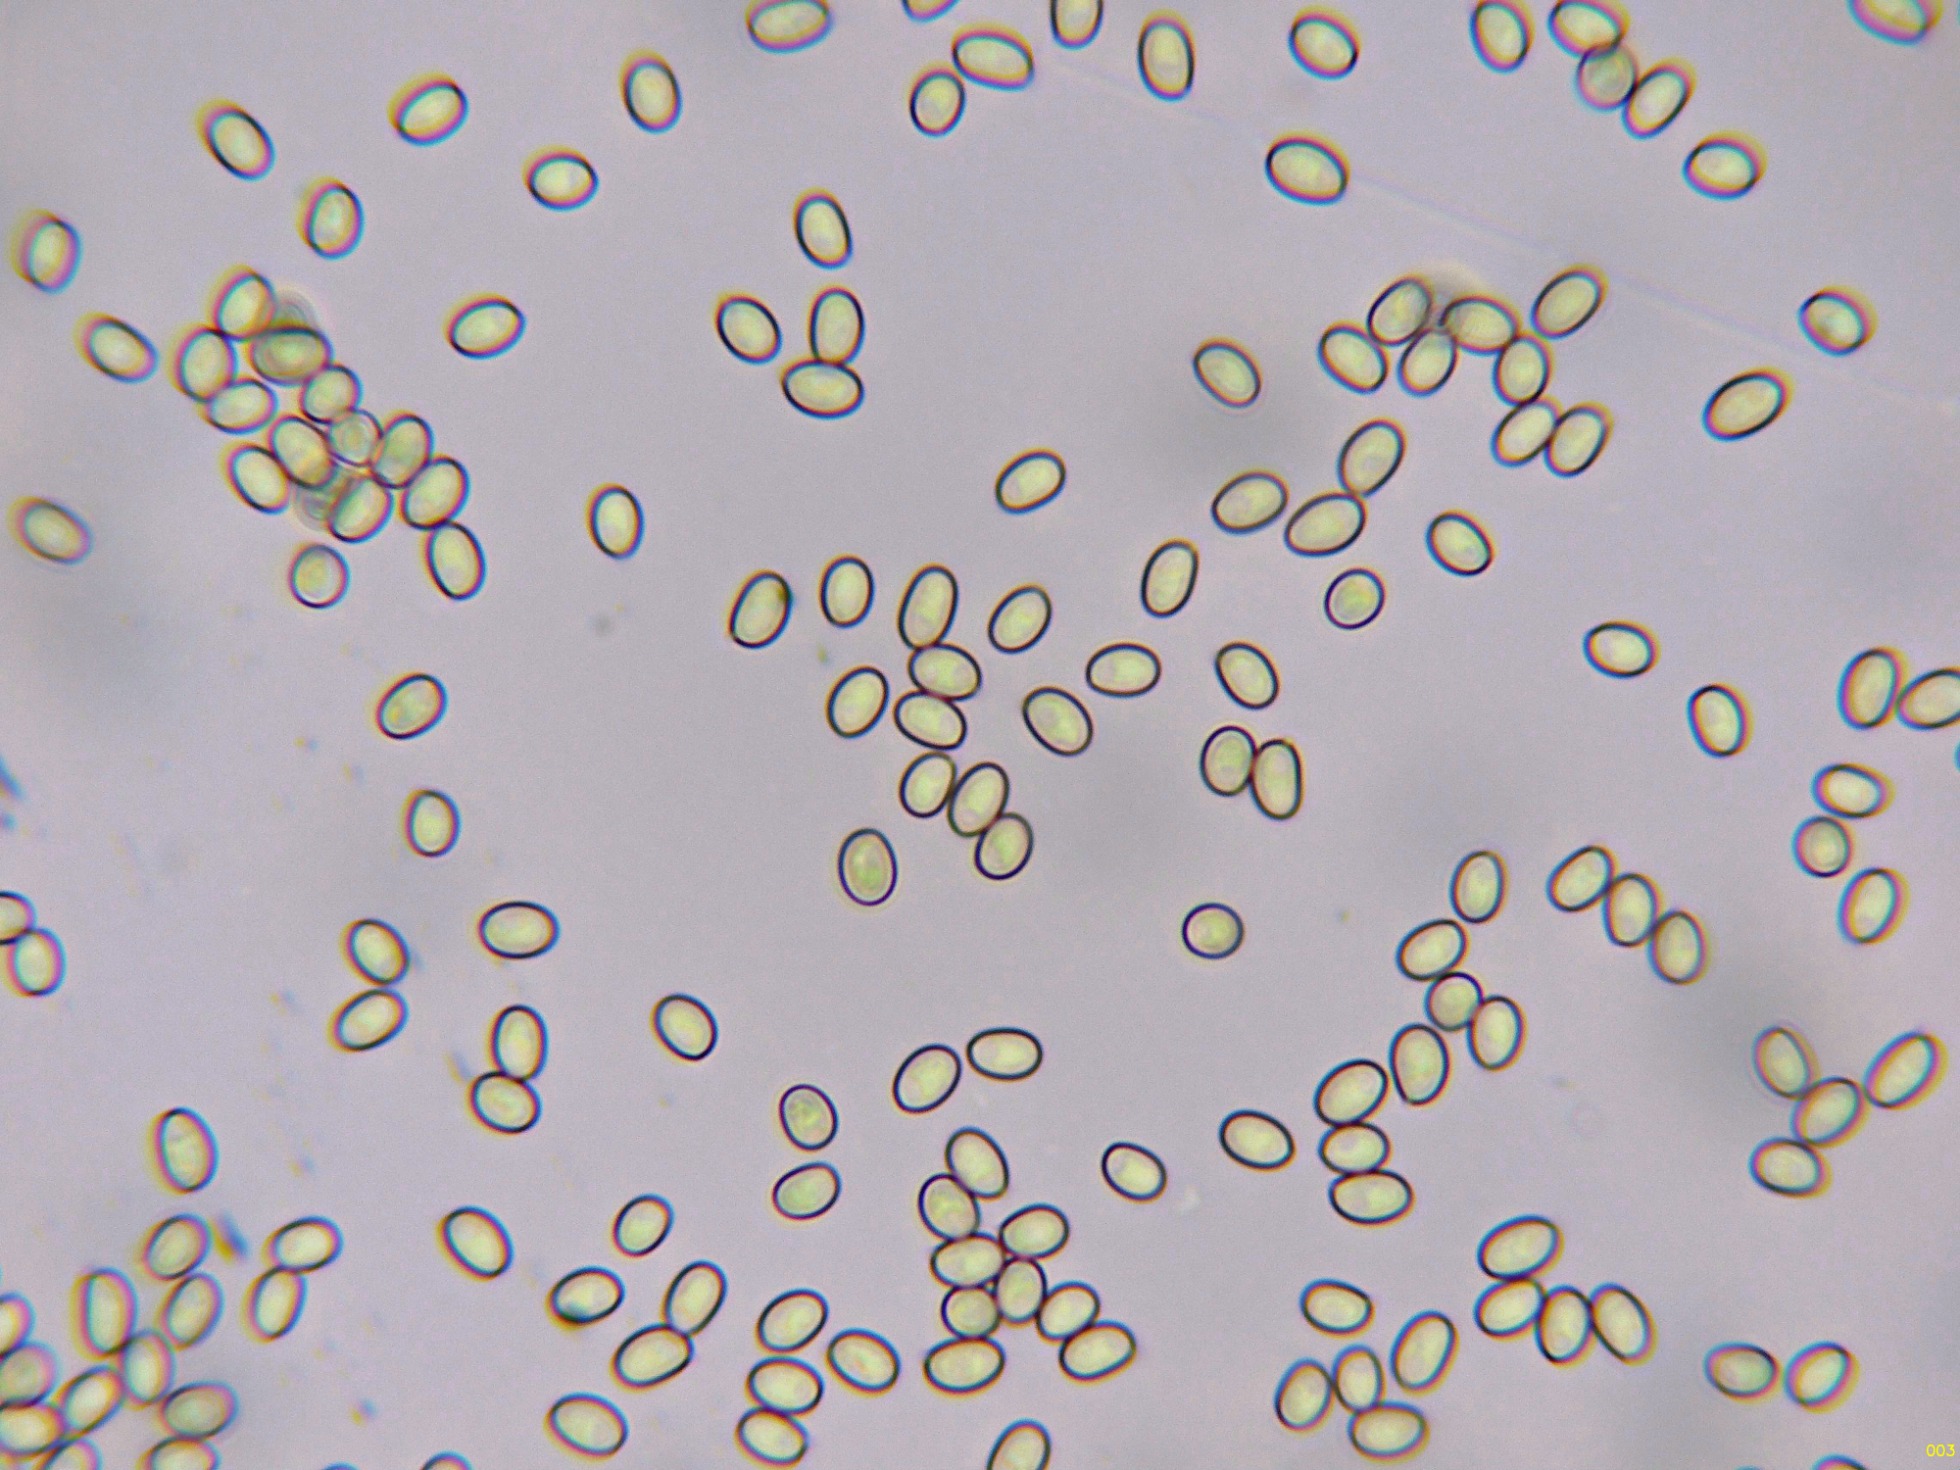
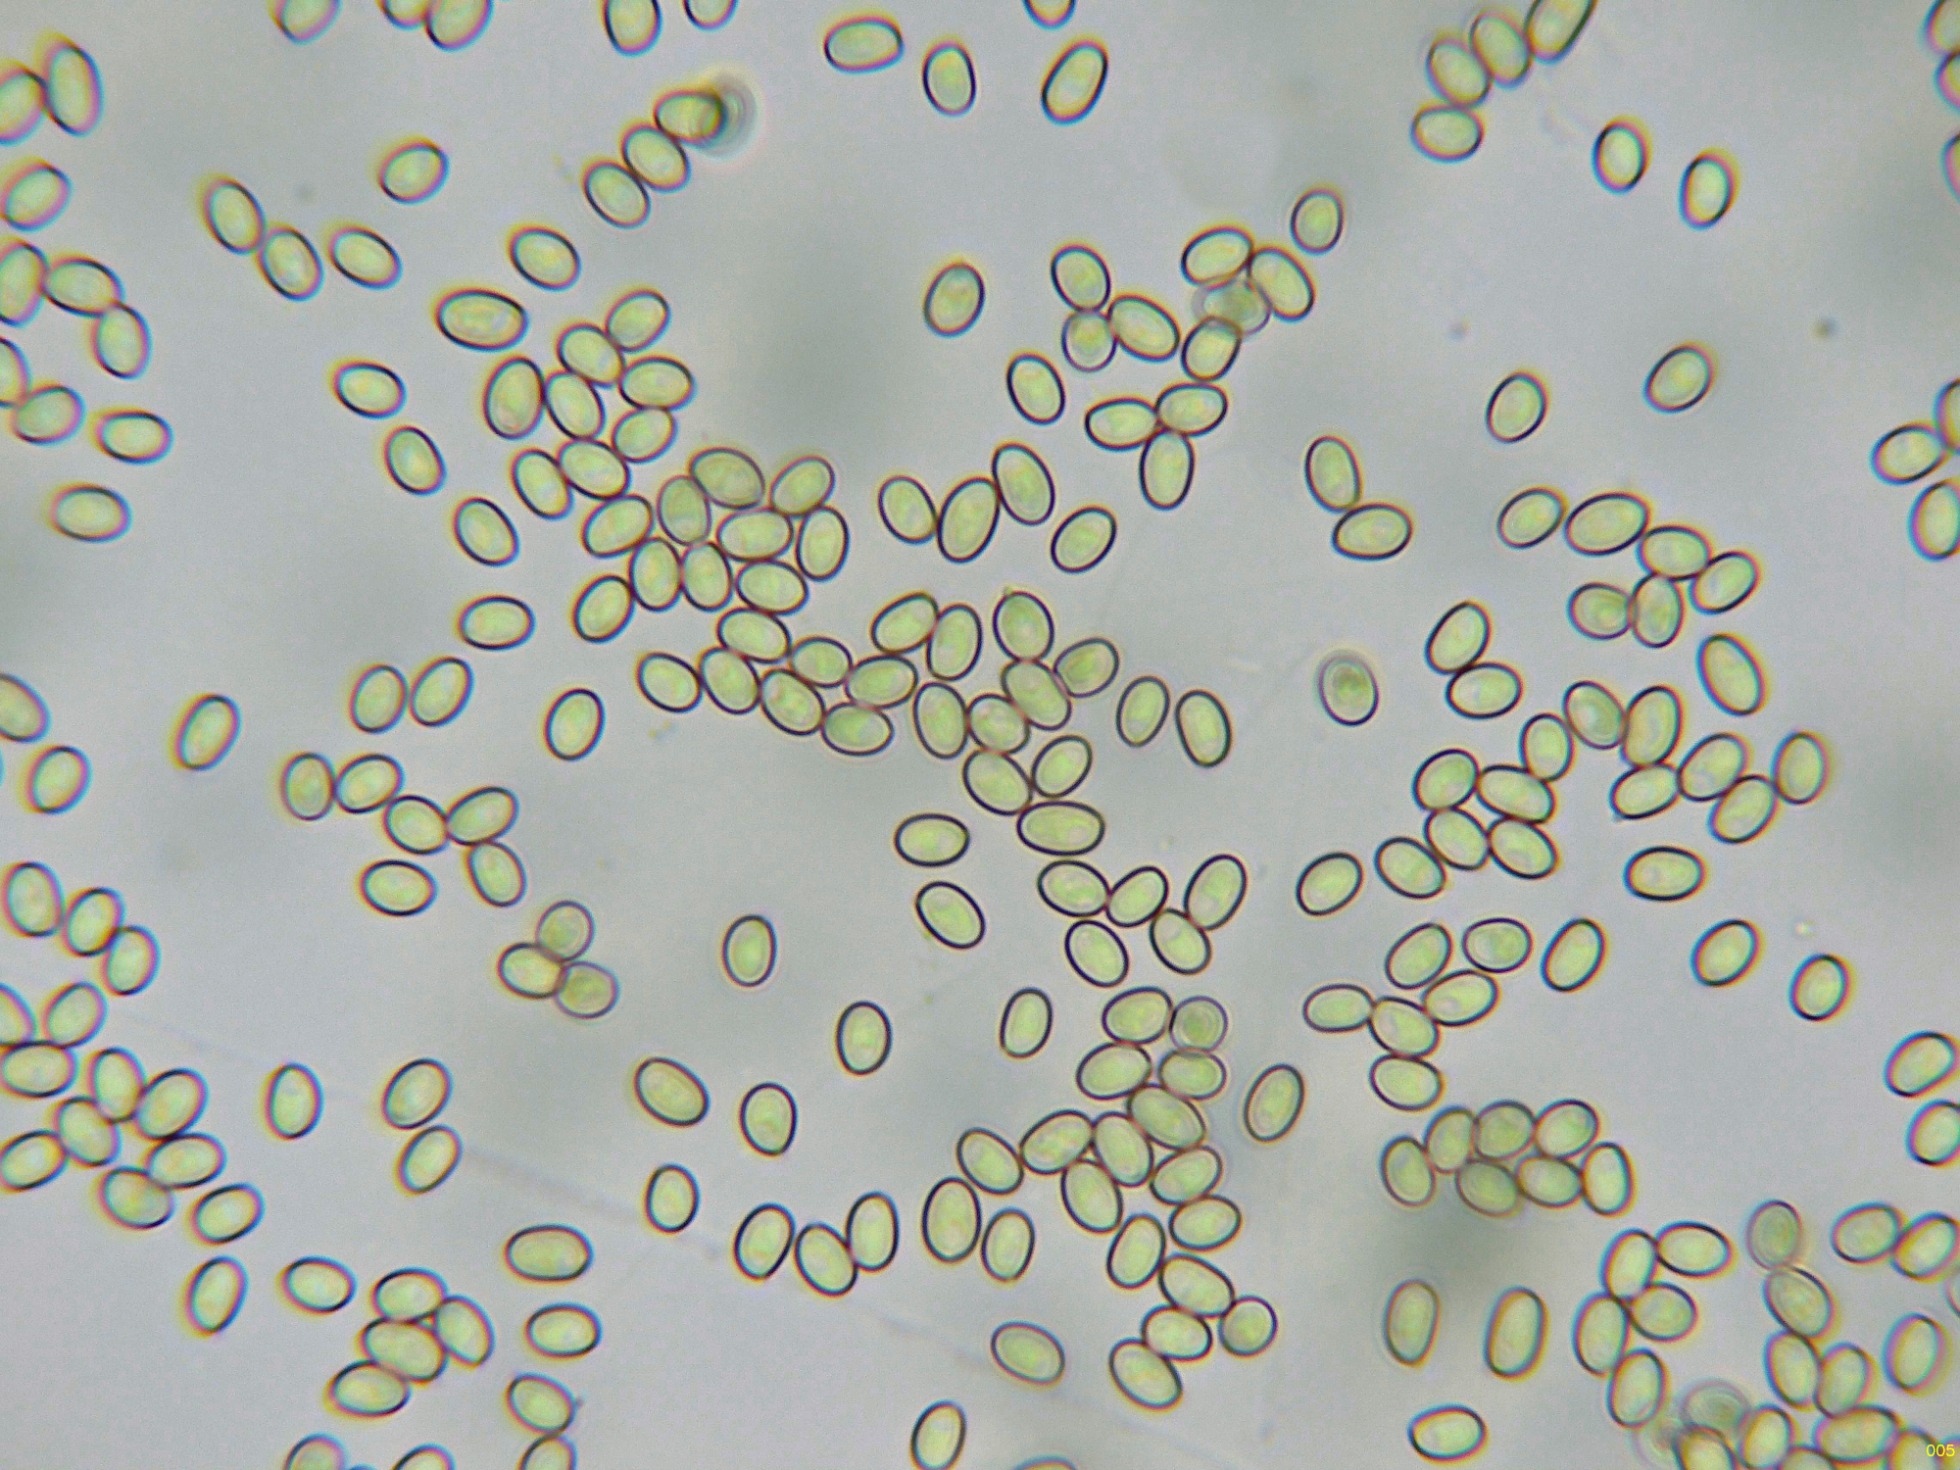

- Foro
- Foros sobre Micología de fungipedia
- Microscopía
- Ya tocaba, por fin: Tapinella panuoides (Fr.) E.-J. Gilbert. Microscopía.
 Ya tocaba, por fin: Tapinella panuoides (Fr.) E.-J. Gilbert. Microscopía.
Ya tocaba, por fin: Tapinella panuoides (Fr.) E.-J. Gilbert. Microscopía.
- Josep Torres
-
 Autor del tema
Autor del tema
- Ausente
- Moderador
-

Menos
Más
- Mensajes: 8746
- Gracias recibidas: 8379
1 año 4 meses antes #110379
por Josep Torres
Ya tocaba, por fin: Tapinella panuoides (Fr.) E.-J. Gilbert. Microscopía. Publicado por Josep Torres
Hola.
Un hongo lignícola que si bien no se considera para nada raro, he tardado 10 años en encontrar, y del que no disponía de su microscopía, brotando de manera abundante sobre un tocón de pino, sobre suelo quemado, aunque esto no tiene nada que ver con la especie, tenemos por fin la:
Tapinella panuoides (Fr.) E.-J. Gilbert.
Especie muy poco agradecida al micro.
Las hifas de la suprapellis en agua con pigmento intracelular ocráceo:
Las hifas de la subpellis en agua, estas hifas ya más hialinas:
Arista laminar sin elementos diferenciados de los basidios o basidiolos:
Los basidios de la cara laminar:
Las esporas en Reactivo de Melzer, con un comportamiento dextrinoide:
Las esporas en agua:
Estas esporas obtenidas por esporulación natural y en agua con unas medidas de:
(4.9) 5 - 5.8 (6.3) × (3.4) 3.5 - 3.9 (4.1) µm
Q = (1.3) 1.4 - 1.6 (1.8) ; N = 40
Me = 5.4 × 3.7 µm ; Qe = 1.5
Saludos
Un hongo lignícola que si bien no se considera para nada raro, he tardado 10 años en encontrar, y del que no disponía de su microscopía, brotando de manera abundante sobre un tocón de pino, sobre suelo quemado, aunque esto no tiene nada que ver con la especie, tenemos por fin la:
Tapinella panuoides (Fr.) E.-J. Gilbert.
Especie muy poco agradecida al micro.
Las hifas de la suprapellis en agua con pigmento intracelular ocráceo:
Las hifas de la subpellis en agua, estas hifas ya más hialinas:
Arista laminar sin elementos diferenciados de los basidios o basidiolos:
Los basidios de la cara laminar:
Las esporas en Reactivo de Melzer, con un comportamiento dextrinoide:
Las esporas en agua:
Estas esporas obtenidas por esporulación natural y en agua con unas medidas de:
(4.9) 5 - 5.8 (6.3) × (3.4) 3.5 - 3.9 (4.1) µm
Q = (1.3) 1.4 - 1.6 (1.8) ; N = 40
Me = 5.4 × 3.7 µm ; Qe = 1.5
Saludos
Adjuntos:
El siguiente usuario dijo gracias: Juan Andrés Román
Por favor, Identificarse para unirse a la conversación.
- Pepe Ferrer
-

- Fuera de línea
- Navegador Dorado
-

Menos
Más
- Mensajes: 211
- Gracias recibidas: 145
1 año 4 meses antes #110380
por Pepe Ferrer
Respuesta de Pepe Ferrer sobre el tema Ya tocaba, por fin: Tapinella panuoides (Fr.) E.-J. Gilbert. Microscopía.
Mi mas sincera enhorabuena. Si, ya era hora. Pero quien la sigue la consigue..Me alegro de corazón.
El siguiente usuario dijo gracias: Juan Andrés Román, Josep Torres
Por favor, Identificarse para unirse a la conversación.
- Josep Torres
-
 Autor del tema
Autor del tema
- Ausente
- Moderador
-

Menos
Más
- Mensajes: 8746
- Gracias recibidas: 8379
1 año 4 meses antes #110381
por Josep Torres
Respuesta de Josep Torres sobre el tema Ya tocaba, por fin: Tapinella panuoides (Fr.) E.-J. Gilbert. Microscopía.
El siguiente usuario dijo gracias: Juan Andrés Román
Por favor, Identificarse para unirse a la conversación.
- Foro
- Foros sobre Micología de fungipedia
- Microscopía
- Ya tocaba, por fin: Tapinella panuoides (Fr.) E.-J. Gilbert. Microscopía.
Tiempo de carga de la página: 0.180 segundos

Foro de micología